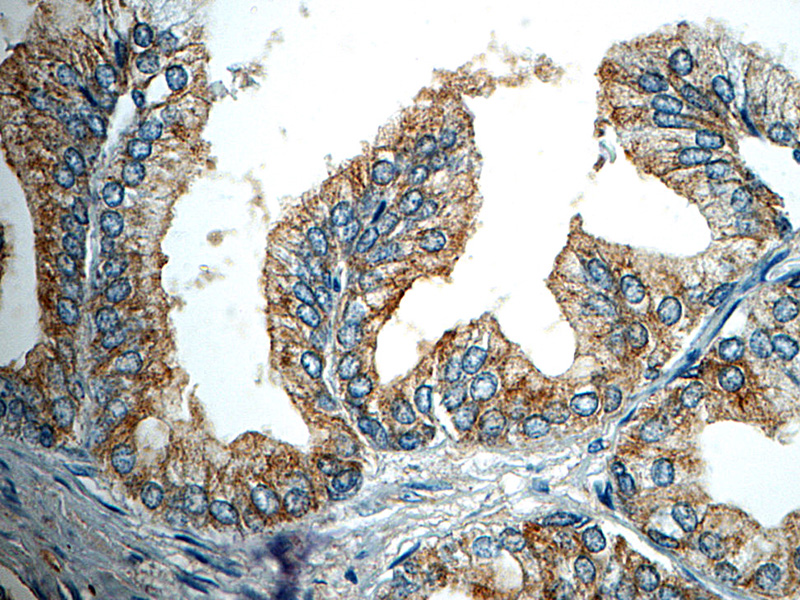
产品细节图片1

相关产品推荐更多 >
万千商家帮你免费找货
0 人在求购买到急需产品
- 详细信息
- 文献和实验
- 技术资料
- 形态:
liquid
- 保存条件:
Store at -20˚C
- 克隆性:
Monoclonal
- 适应物种:
Human
- 保质期:
12 months
- 抗原来源:
Mouse
- 供应商:
南京赛戈巍生物科技有限公司
- 宿主:
Mouse
- 应用范围:
IHC
- 抗体英文名:
Nerve Growth Factor Receptor (NGFR) Antibody
- 规格:
50ul/100ul
应用详情:Recommended working dilution range:1:100 - 1:200
图片:
Nerve Growth Factor Receptor Antibody (P1020) on Prostate
风险提示:丁香通仅作为第三方平台,为商家信息发布提供平台空间。用户咨询产品时请注意保护个人信息及财产安全,合理判断,谨慎选购商品,商家和用户对交易行为负责。对于医疗器械类产品,请先查证核实企业经营资质和医疗器械产品注册证情况。
文献和实验to establish that antibodies targeting the epidermal growth factor receptor and vascular endothelial growth factor receptor-2 are synergistic with regard to antitumor effects, in a BxPC-3 subcutaneous xenograft model for pancreatic cancer.
略称NGF。在将小鼠肉瘤180移植于3日龄鸡胚体壁时,与移植片连接的脊髓感觉神经节及交感神经节增大20%—40%,基于比克尔(E.D.Bueker,1948)的这一发现,科恩(S.Cohen,1954)等从小鼠肉瘤180和37中成功地分离出具有同一活性的核蛋白质,以后从蛇毒中分离出具有千倍活性(Cohen,R.Levi-Montalcini,1956)和从小鼠颚下腺分离出具有万倍活性的蛋白质(Cohen,1960),这种蛋白质被称为神经生长因子。科恩等认为,其有效成分是分子量约为2.2万
Silencing Epidermal Growth Factor Receptor by RNA Interference in Glioma
growth factor receptor (EGFR) has been shown to be overexpressed in a variety of tumors and is one of the important mediators responsible for the development of high-grade gliomas, especially in primary glioblastomas. Most recently, RNA interference (RNAi
技术资料暂无技术资料 索取技术资料





![LMAN1 Rabbit Polyclonal Antibody[53164]](https://img1.dxycdn.com/p/s14/2025/0922/498/0460884283108299691.jpg!wh200)

![CIAPIN1 Antibody[36352]](https://img1.dxycdn.com/p/s14/2025/0922/359/6146153295428599691.jpg!wh200)
